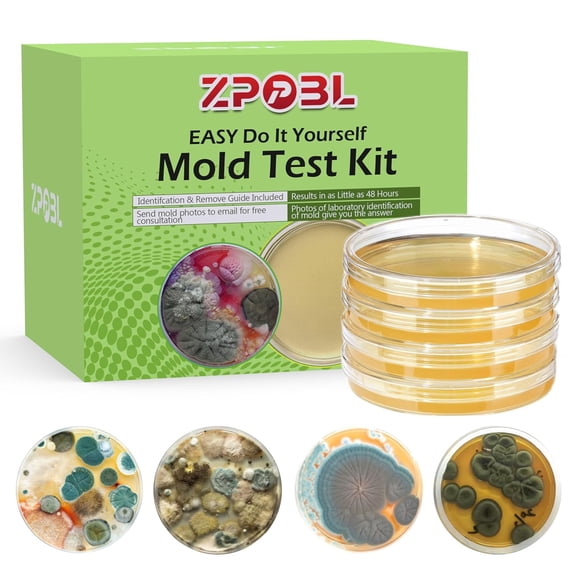
Mold Test Kit for Home, 4 Detection Tests for HVAC, Surfaces & Indoor Air Quality, DIY Black Home Mold Detector Testing kit, Identification Guide & Free Lab Analysis Included

Air Quality Testing(194)
Uses item details. Price when purchased online
Mold Test Company DIY Mold Air Detection Test Kit $19.95

Sponsored
$1995
current price $19.95Mold Test Company DIY Mold Air Detection Test Kit
243.7 out of 5 Stars. 24 reviews
Save with
Mold Test Kit for Home Detection: 8 Simple DIY Science Kits for Fastly Testing Home Surfaces & Air Quality Detector & HVAC Monitor Includes Detailed Identification Guide From $16.99

Sponsored
From$1699
Mold Test Kit for Home Detection: 8 Simple DIY Science Kits for Fastly Testing Home Surfaces & Air Quality Detector & HVAC Monitor Includes Detailed Identification Guide
63.8 out of 5 Stars. 6 reviews
Clean Vent Air Air Vent Mold Detection Test Kit $19.99

Sponsored
$1999
current price $19.99Clean Vent Air Air Vent Mold Detection Test Kit
54.2 out of 5 Stars. 5 reviews
Mold Test Kit for Home Within 2 Individual Tests,Test HVAC,Home Surfaces,Indoor Air Quality Testing Kits,Skin Test,DIY Black Mold Detector Testing kit,Mold Identification Guide-Free Lab Analysis $16.13

Sponsored
$1613
current price $16.13Mold Test Kit for Home Within 2 Individual Tests,Test HVAC,Home Surfaces,Indoor Air Quality Testing Kits,Skin Test,DIY Black Mold Detector Testing kit,Mold Identification Guide-Free Lab Analysis
44 out of 5 Stars. 4 reviews
Save with
Airthings Wave Mini - Indoor Air Quality Monitor with Mold-Risk Indication $69.69 Was $79.99

Now$6969
current price Now $69.69, Was $79.99$79.99
Airthings Wave Mini - Indoor Air Quality Monitor with Mold-Risk Indication
444.4 out of 5 Stars. 44 reviews
Save with
15in1 for Smart Air Quality Monitor Air Quality Tester Real Time For Home And Office

15in1 for Smart Air Quality Monitor Air Quality Tester Real Time For Home And Office
PRO-LAB Mold Detection Test Kit for Air and Surfaces $12.97

$1297
current price $12.97PRO-LAB Mold Detection Test Kit for Air and Surfaces
1783.9 out of 5 Stars. 178 reviews
Mold Test Kit for Home Within 2 Individual Tests,Test HVAC,Home Surfaces,Indoor Air Quality Testing Kits,Skin Test,DIY Black Mold Detector Testing kit,Mold Identification Guide-Free Lab Analysis $16.13

$1613
current price $16.13Mold Test Kit for Home Within 2 Individual Tests,Test HVAC,Home Surfaces,Indoor Air Quality Testing Kits,Skin Test,DIY Black Mold Detector Testing kit,Mold Identification Guide-Free Lab Analysis
44 out of 5 Stars. 4 reviews
Save with
Best seller MOLD ARMOR Do-It-Yourself Mold Detection Test Kit $11.97

$1197
current price $11.97MOLD ARMOR Do-It-Yourself Mold Detection Test Kit
1484.2 out of 5 Stars. 148 reviews
Save with
Mold Test Kit for Home Within 5 Individual Tests,Test HVAC,Home Surfaces,Indoor Air Quality Testing Kits,Skin Test,DIY Black Mold Detector Testing kit,Mold Identification Guide-Free Lab Analysis $24.63

Sponsored
$2463
current price $24.63Mold Test Kit for Home Within 5 Individual Tests,Test HVAC,Home Surfaces,Indoor Air Quality Testing Kits,Skin Test,DIY Black Mold Detector Testing kit,Mold Identification Guide-Free Lab Analysis
34.3 out of 5 Stars. 3 reviews
Save with
Immunolytics DIY Mold Test Kit - Easy to Use Professional 5 Plate Room Screening Kit $39.00

Sponsored
$3900
current price $39.00Immunolytics DIY Mold Test Kit - Easy to Use Professional 5 Plate Room Screening Kit
314.2 out of 5 Stars. 31 reviews
Indoor Air Quality Detector High- Real-Time Portable 10-in-1 Monitor with Alarm Air Quality Tester Indoor B $24.08

$2408
current price $24.08Indoor Air Quality Detector High- Real-Time Portable 10-in-1 Monitor with Alarm Air Quality Tester Indoor B
14 out of 5 Stars. 1 reviews
Neorosiri 5-in-1 Indoor Air Quality Monitor,HCHO TVOC CO2 Detector,Rechargeable LED Display,Alarm Function

Neorosiri 5-in-1 Indoor Air Quality Monitor,HCHO TVOC CO2 Detector,Rechargeable LED Display,Alarm Function
23 out of 5 Stars. 2 reviews
Mold Test Company DIY Mold Air Detection Test Kit $19.95

$1995
current price $19.95Mold Test Company DIY Mold Air Detection Test Kit
243.7 out of 5 Stars. 24 reviews
Save with
Clean Vent Air Air Vent Mold Detection Test Kit $19.99

$1999
current price $19.99Clean Vent Air Air Vent Mold Detection Test Kit
54.2 out of 5 Stars. 5 reviews
MT07WT 6-in-1 Indoor Air Quality Monitor Portable PM2.5 Tester Household HCHO TVOC CO2 Temperature Humidity Tester White $18.06

$1806
current price $18.06MT07WT 6-in-1 Indoor Air Quality Monitor Portable PM2.5 Tester Household HCHO TVOC CO2 Temperature Humidity Tester White
Mold Test Kit for Home Within 5 Individual Tests,Test HVAC,Home Surfaces,Indoor Air Quality Testing Kits,Skin Test,DIY Black Mold Detector Testing kit,Mold Identification Guide-Free Lab Analysis $24.63

$2463
current price $24.63Mold Test Kit for Home Within 5 Individual Tests,Test HVAC,Home Surfaces,Indoor Air Quality Testing Kits,Skin Test,DIY Black Mold Detector Testing kit,Mold Identification Guide-Free Lab Analysis
34.3 out of 5 Stars. 3 reviews
Save with
Formaldehyde Detector for Household Professional Self-Test Indoor Air Quality Testing Formaldehyde Content RC3001 $11.39

$1139
current price $11.39Formaldehyde Detector for Household Professional Self-Test Indoor Air Quality Testing Formaldehyde Content RC3001
11 out of 5 Stars. 1 reviews
1-Room Mold Test Kit $69.99

Sponsored
$6999
current price $69.991-Room Mold Test Kit
FLAZECON Air Quality Monitor Indoor, 5 in 1 Portable Real-Time Smart Air Quality Tester with CO2 Monitor, HCHO, TVOC, Temperature, Humidity Detector for Home, Office, Car, Hotel $29.99

$2999
current price $29.99FLAZECON Air Quality Monitor Indoor, 5 in 1 Portable Real-Time Smart Air Quality Tester with CO2 Monitor, HCHO, TVOC, Temperature, Humidity Detector for Home, Office, Car, Hotel
Indoor Air Quality Meter $376.49

$37649
current price $376.49Indoor Air Quality Meter
GJX Multifunctional LCD Digital Display Portable Carbon Dioxide Meter Temperature And Humidity Tester Air Quality Monitoring Analyzer, Wide Use $15.63

$1563
current price $15.63GJX Multifunctional LCD Digital Display Portable Carbon Dioxide Meter Temperature And Humidity Tester Air Quality Monitoring Analyzer, Wide Use
Mold Test Kit for Home - 12 Simple Detection Tests,Test HVAC System,Home Surfaces,& Indoor Air Quality Testing Kits,DIY Mold Detector at Home,Includes Detailed Mold Identification Guide,air Tester $38.15

$3815
current price $38.15Mold Test Kit for Home - 12 Simple Detection Tests,Test HVAC System,Home Surfaces,& Indoor Air Quality Testing Kits,DIY Mold Detector at Home,Includes Detailed Mold Identification Guide,air Tester
Air Monitor Lite, Apple HomeKit Compatible Wi-Fi Indoor Air Quality Meter Detects Home CO2, PM2.5, PM10, Temperature, and Humidity$$Other $110.20

$11020
current price $110.20Air Monitor Lite, Apple HomeKit Compatible Wi-Fi Indoor Air Quality Meter Detects Home CO2, PM2.5, PM10, Temperature, and Humidity$$Other
Airthings View Plus Complete Indoor Air Quality Monitor - 2960 $325.00

$32500
current price $325.00Airthings View Plus Complete Indoor Air Quality Monitor - 2960
424.5 out of 5 Stars. 42 reviews
Save with
Air Quality Detector HCHO Formaldehyde PM2.5 PM10 TVOC Real-Time Monitor with Temperature and Humidity Was $58.99

Air Quality Detector HCHO Formaldehyde PM2.5 PM10 TVOC Real-Time Monitor with Temperature and Humidity
Mold Test Kit for Home, 4 Detection Tests for HVAC, Surfaces & Indoor Air Quality, DIY Black Home Mold Detector Testing kit, Identification Guide & Free Lab Analysis Included $19.99
$1999
current price $19.99Mold Test Kit for Home, 4 Detection Tests for HVAC, Surfaces & Indoor Air Quality, DIY Black Home Mold Detector Testing kit, Identification Guide & Free Lab Analysis Included
Temtop C1 CO2 Monitor Indoor air Quality Monitor Portable CO2 Meter, CO2, Temperature, Humidity Home, Office or School

2 options
Available in additional 2 optionsTemtop C1 CO2 Monitor Indoor air Quality Monitor Portable CO2 Meter, CO2, Temperature, Humidity Home, Office or School
Indoor Air Quality Monitor for PM2.5/PM10 CO2 Formaldehyde /HCHO TVOC Home Use

Indoor Air Quality Monitor for PM2.5/PM10 CO2 Formaldehyde /HCHO TVOC Home Use
44.5 out of 5 Stars. 4 reviews
Datalogging Indoor Air Quality Meter $379.50

$37950
current price $379.50Datalogging Indoor Air Quality Meter
Temtop Air Quality Monitor LKC-1000S+ 2nd PM2.5 PM10 Formaldehyde Temperature and Humidity TVOC AQI Tester Indoor Outdoor Air Pollution Detector w/ Data Export

Temtop Air Quality Monitor LKC-1000S+ 2nd PM2.5 PM10 Formaldehyde Temperature and Humidity TVOC AQI Tester Indoor Outdoor Air Pollution Detector w/ Data Export
32.3 out of 5 Stars. 3 reviews
Air quality detector,Portable Co2 Tester Office Tvoc Temperature 5-in-1 Indoor Air Car Air Quality

Air quality detector,Portable Co2 Tester Office Tvoc Temperature 5-in-1 Indoor Air Car Air Quality
Mold Test Kit for by - with 4 Mold Detection + 4 Detection Tests for HVAC, Surfaces, & Indoor Air Quality - DIY Kit inlcudes Detailed Guide & Free Consultation

Mold Test Kit for by - with 4 Mold Detection + 4 Detection Tests for HVAC, Surfaces, & Indoor Air Quality - DIY Kit inlcudes Detailed Guide & Free Consultation
AIRKNIGHT 9-In-1 Indoor Air Quality Monitor Indoor Portable CO2 Monitor, VOC Sensor, Formaldehyde Detector, AQI, PM2.5 + 4 More Home Monitoring, Air Quality Tester Confined Space Clean Air Monitor $89.99 Was $121.49

Now$8999
current price Now $89.99, Was $121.49$121.49
AIRKNIGHT 9-In-1 Indoor Air Quality Monitor Indoor Portable CO2 Monitor, VOC Sensor, Formaldehyde Detector, AQI, PM2.5 + 4 More Home Monitoring, Air Quality Tester Confined Space Clean Air Monitor
584 out of 5 Stars. 58 reviews
Save with
TECHTONGDA Formaldehyde Monitor Air Quality Monitor Home Air Quality Particle Detector Handheld High-Precision Formaldehyde Detector $49.00

$4900
current price $49.00TECHTONGDA Formaldehyde Monitor Air Quality Monitor Home Air Quality Particle Detector Handheld High-Precision Formaldehyde Detector
Air Quality Tester Formaldehyde HCHO TVOC AQI Detector Multifunctional Air Gas Detector Comfort Display Portable $19.59

$1959
current price $19.59Air Quality Tester Formaldehyde HCHO TVOC AQI Detector Multifunctional Air Gas Detector Comfort Display Portable
Air Quality Monitor 5 in 1 Air Quality Detector C02 Detector HCHO TVOC Tester LCD Temperature Humidity Tester Black,1 x Air Quality Detector,Black $13.79

$1379
current price $13.79Air Quality Monitor 5 in 1 Air Quality Detector C02 Detector HCHO TVOC Tester LCD Temperature Humidity Tester Black,1 x Air Quality Detector,Black
OAVQHLG3B Formaldehyde Detector Haze Indoor Air Quality Testing Instrument $46.36

$4636
current price $46.36OAVQHLG3B Formaldehyde Detector Haze Indoor Air Quality Testing Instrument
Air Mold Test Kit - Evviva Sciences - 5 Simple Mold Detection Tests - Optional Lab Analysis - Test HVAC System, Room Air, & Home Surfaces - Includes Detailed Mold ID Guide $24.99

$2499
current price $24.99Air Mold Test Kit - Evviva Sciences - 5 Simple Mold Detection Tests - Optional Lab Analysis - Test HVAC System, Room Air, & Home Surfaces - Includes Detailed Mold ID Guide
184.4 out of 5 Stars. 18 reviews
PM2.5 Dust Detector, Household Indoor Laser Meter, Air Quality Testing Instrument, Gas Detector $30.81

$3081
current price $30.81PM2.5 Dust Detector, Household Indoor Laser Meter, Air Quality Testing Instrument, Gas Detector
Temtop M10+ Indoor Air Quality Monitor, 6-in-1 CO2, PM2.5, VOC Detection, Smart Temperature & Humidity Sensor, with App Connectivity for Home Air Quality Testing & Analysis $129.99

$12999
current price $129.99Temtop M10+ Indoor Air Quality Monitor, 6-in-1 CO2, PM2.5, VOC Detection, Smart Temperature & Humidity Sensor, with App Connectivity for Home Air Quality Testing & Analysis
Meter 9 In 1 Air Quality Tester Clear Display Large Digital Screen With Backlight CO2 PM2.5 Air Detector White $31.08 Was $36.99

Now$3108
current price Now $31.08, Was $36.99$36.99
Meter 9 In 1 Air Quality Tester Clear Display Large Digital Screen With Backlight CO2 PM2.5 Air Detector White
Air quality detector,Tester Office Air Quality Temperature Tvoc 5-in-1 Indoor Air Car Portable Co2 Quality Portable

Air quality detector,Tester Office Air Quality Temperature Tvoc 5-in-1 Indoor Air Car Portable Co2 Quality Portable
Indoor Air Quality Detector High- Real-Time Portable 10-in-1 Monitor with Alarm Air Quality Tester Indoor A $27.31

$2731
current price $27.31Indoor Air Quality Detector High- Real-Time Portable 10-in-1 Monitor with Alarm Air Quality Tester Indoor A
Popular in Air Quality Testing
Related Products
Qzbhct 14 Pack Activated Carbon Filters Compatible with Hakko Xytronic Aoyue Smoke Absorber, 5 1/8 Inch x 5 1/8 Inch Solder Extractor Filter
Qzbhct 14 Pack Activated Carbon Filters Compatible with Hakko Xytronic Aoyue Smoke Absorber, 5 1/8 Inch x 5 1/8 Inch Solder Extractor Filter$24.99current price $24.99Allegro-2050 Fit Testing Kit, Irritant Smoke,one size
Allegro-2050 Fit Testing Kit, Irritant Smoke,one size$85.08current price $85.08Gas tester,Natural Tester Portable Test And Sound Alarm Handheld Combustible Leak With Temperature Test Combustible Leak Natural Tester Portable Combustible Huiop Buzhi Function Black & Red
Gas tester,Natural Tester Portable Test And Sound Alarm Handheld Combustible Leak With Temperature Test Combustible Leak Natural Tester Portable Combustible Huiop Buzhi Function Black & Red$33.04current price $33.04Mitco N27-16M: Complete Combustion Smoke Test Kit
Mitco N27-16M: Complete Combustion Smoke Test Kit$147.24current price $147.24Gas tester,Meter Combustible Pen Portable Ppm Meter Handheld Combustible Leak Combustible Leak Natural Leak Natural Tester Natural Tester Portable Tester Portable Ppm Papapi Multicolor HT60
Gas tester,Meter Combustible Pen Portable Ppm Meter Handheld Combustible Leak Combustible Leak Natural Leak Natural Tester Natural Tester Portable Tester Portable Ppm Papapi Multicolor HT60$17.28current price $17.28ResOne High Flow Liter Meter Pen: Measure Oxygen Flow Rates 2-15 LPM
ResOne High Flow Liter Meter Pen: Measure Oxygen Flow Rates 2-15 LPM$9.99current price $9.992 Pieces Humidifier Auto Relay Tester Hardness High Accuracy
2 Pieces Humidifier Auto Relay Tester Hardness High Accuracy$53.00current price $53.00B3C Fuel Solutions DEF Contamination Test Strips 100 Count, Diesel Exhaust Fluid Purity Tester for Trucks, Fleets, Heavy Equipment, Fast On-Site Results
B3C Fuel Solutions DEF Contamination Test Strips 100 Count, Diesel Exhaust Fluid Purity Tester for Trucks, Fleets, Heavy Equipment, Fast On-Site Results$60.98current price $60.98ResOne Standard Liter Meter Pen: Measure Oxygen Flow Rates Up To 8 LPM
ResOne Standard Liter Meter Pen: Measure Oxygen Flow Rates Up To 8 LPM$9.99current price $9.99Elitech IR-200 Infrared & Heated Diode Refrigerant Leak Detector for Air Conditioner and Automotive Repair
Elitech IR-200 Infrared & Heated Diode Refrigerant Leak Detector for Air Conditioner and Automotive Repair$319.99current price $319.99Temtop Advanced Air Quality Monitor for CO2, PM2.5, PM10, with Audio Alarm, Temp & Humidity Insights, Plus Data Export for In-depth Analysis, M2000C 2ND
Temtop Advanced Air Quality Monitor for CO2, PM2.5, PM10, with Audio Alarm, Temp & Humidity Insights, Plus Data Export for In-depth Analysis, M2000C 2ND$189.99current price $189.99Tester,Alarm And Data Air Quality Carbon Dioxide Co2 Indoor Air Data Voc Carbon With App Alarm And Data Voc Temperature Voc Carbon Dioxide Quality Indoor App Alarm And version
Tester,Alarm And Data Air Quality Carbon Dioxide Co2 Indoor Air Data Voc Carbon With App Alarm And Data Voc Temperature Voc Carbon Dioxide Quality Indoor App Alarm And version$25.59current price $25.59AUTOOL Car Smoke Machine, EVAP Smoke Leak Detector, DC 12V Automotive Smoke Leak Machine, Portable Fuel Pipe Vacuum Smoke Diagnostic for Cars Motorcycles Trucks
AUTOOL Car Smoke Machine, EVAP Smoke Leak Detector, DC 12V Automotive Smoke Leak Machine, Portable Fuel Pipe Vacuum Smoke Diagnostic for Cars Motorcycles Trucks$51.99current price $51.99Spectroline Fluorescent Leak Detect Kit,Green,0.5 oz SPE-HVLGSE
Spectroline Fluorescent Leak Detect Kit,Green,0.5 oz SPE-HVLGSE$196.51current price $196.51









